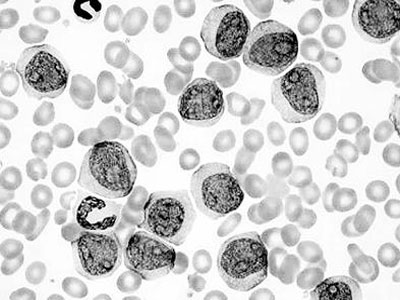
染色质基因分析可识别癌症起源

人体x染色质绘图

18,x染色人类染色体g显带标本的制备及观察ppt
图片尺寸1080x810
染色体和染色质的关系是( )
图片尺寸475x186
性染色质标本的制备和观察
图片尺寸671x381
人体的每个细胞都有23对染色体吗?
图片尺寸616x407
中山大学人类x染色质标本地制备与观察报告docx6页
图片尺寸860x1218
表观遗传学(研究生课件) x染色质 失活的x染色体被称为barr body
图片尺寸1080x810
染色质纤维缠绕成染色体时为何不会相互打结?
图片尺寸640x640
人x染色质装片细胞生物学与遗传学生物切片标本显微镜玻片
图片尺寸750x750
染色体人染色体
图片尺寸440x310
白天,正面,数码,科技,阴影,黑色背景,科学,网络,基因,细胞核,染色体
图片尺寸819x614
遗传学实验报告 实验一:x染色质标本的制备及分析
图片尺寸960x1280
白天,正面,仪器,蓝色背景,检查,反射,分析,科学,基因,细胞核,染色体
图片尺寸819x819
《人类染色体与染色体病》学习笔记_为什么x染色质数等于x染色体数减1
图片尺寸902x420
biorxiv高通量单细胞染色质图谱研究人体免疫细胞发育和肿瘤内t细胞
图片尺寸1104x1206
x小体,x染色质
图片尺寸423x429
自由基影响除了紫外线之外,抽烟,喝酒等都会加速人体衰老.
图片尺寸660x545
染色质基因分析可识别癌症起源
图片尺寸400x300
下图表示人体骨髓造血干细胞的生命历程请据图回答
图片尺寸359x358
cell重磅成果任兵课题组绘制迄今最大规模人类单细胞染色质可及性图谱
图片尺寸670x670
biorxiv高通量单细胞染色质图谱研究人体免疫细胞发育和肿瘤内t细胞
图片尺寸1108x1302